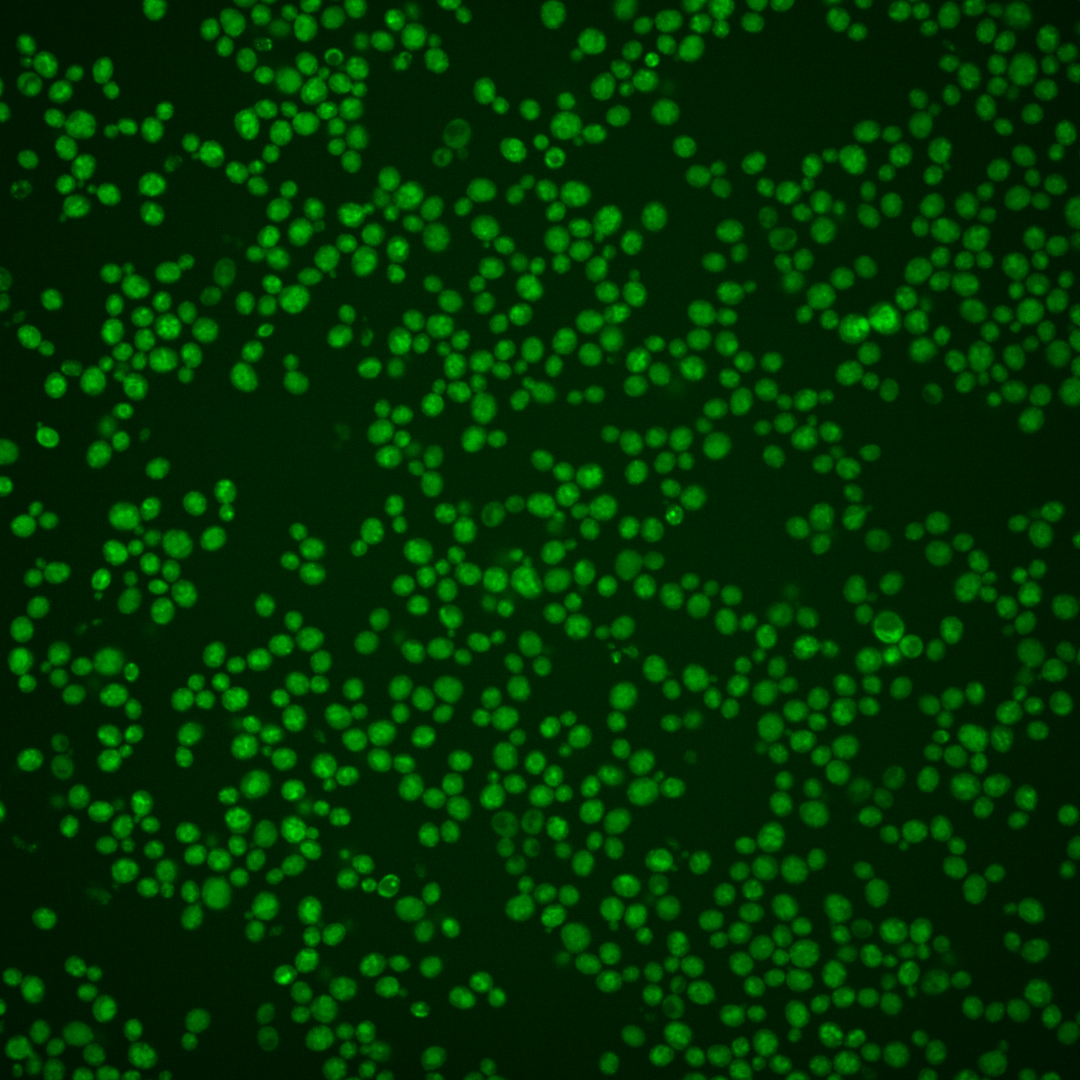

| Standard name | |
|---|---|
| Human Ortholog | |
| Description | Endosomal protein involved in turnover of plasma membrane proteins; member of the DUP380 subfamily of conserved, often subtelomeric COS genes; required for the multivesicular vesicle body sorting pathway that internalizes plasma membrane proteins for degradation; Cos proteins provide ubiquitin in trans for nonubiquitinated cargo proteins |
Micrographs




















































































Sub-cellular Localization
Yeast GFP Assignment
Protein Abundance
Localization Change
External localization resources
| ensLOC | DeepLoc | |||||||||||||||||||||||
|---|---|---|---|---|---|---|---|---|---|---|---|---|---|---|---|---|---|---|---|---|---|---|---|---|
| Localization | WT1 | WT2 | WT3 | RAP60 | RAP140 | RAP220 | RAP300 | RAP380 | RAP460 | RAP540 | RAP620 | RAP700 | HU80 | HU120 | HU160 | rpd3Δ_1 | rpd3Δ_2 | rpd3Δ_3 | WT1 | WT2 | WT3 | AF100 | AF140 | AF180 |
| Cortical Patches | 1 | 0 | 0 | 0 | 0 | 0 | 1 | 0 | 0 | 0 | 0 | 1 | 1 | 3 | 9 | 0 | 0 | 0 | 0 | 0 | 1 | 0 | 2 | 0 |
| Bud | 0 | 0 | 1 | 0 | 1 | 5 | 8 | 9 | 11 | 7 | 10 | 12 | 0 | 6 | 4 | 0 | 0 | 0 | 5 | 5 | 6 | 4 | 8 | 9 |
| Bud Neck | 0 | 0 | 0 | 0 | 0 | 0 | 0 | 0 | 0 | 1 | 0 | 0 | 0 | 0 | 0 | 1 | 0 | 0 | 0 | 1 | 0 | 0 | 2 | 0 |
| Bud Site | 0 | 0 | 0 | 0 | 0 | 0 | 0 | 0 | 0 | 0 | 0 | 0 | 0 | 0 | 0 | 0 | 0 | 0 | – | – | – | – | – | – |
| Cell Periphery | 0 | 0 | 1 | 0 | 0 | 0 | 1 | 0 | 0 | 0 | 1 | 0 | 1 | 2 | 0 | 1 | 0 | 1 | 0 | 0 | 0 | 0 | 0 | 0 |
| Cytoplasm | 52 | 136 | 97 | 235 | 329 | 293 | 374 | 435 | 524 | 532 | 553 | 687 | 266 | 325 | 374 | 188 | 185 | 202 | 6 | 7 | 7 | 7 | 7 | 10 |
| Endoplasmic Reticulum | 3 | 5 | 6 | 1 | 14 | 6 | 8 | 2 | 5 | 3 | 2 | 3 | 7 | 48 | 39 | 7 | 19 | 15 | 7 | 15 | 11 | 15 | 17 | 8 |
| Endosome | 14 | 21 | 15 | 3 | 10 | 2 | 1 | 4 | 2 | 4 | 2 | 0 | 33 | 37 | 60 | 6 | 7 | 3 | 15 | 18 | 11 | 14 | 27 | 20 |
| Golgi | 4 | 4 | 0 | 0 | 1 | 0 | 0 | 0 | 0 | 0 | 0 | 0 | 0 | 0 | 0 | 5 | 1 | 3 | 4 | 2 | 0 | 0 | 5 | 2 |
| Mitochondria | 19 | 2 | 54 | 10 | 26 | 81 | 114 | 113 | 162 | 154 | 188 | 249 | 0 | 0 | 0 | 11 | 6 | 7 | 7 | 3 | 4 | 4 | 6 | 9 |
| Nucleus | 50 | 32 | 53 | 39 | 36 | 106 | 101 | 136 | 112 | 96 | 66 | 77 | 4 | 6 | 7 | 72 | 58 | 46 | 5 | 2 | 0 | 5 | 2 | 2 |
| Nuclear Periphery | 2 | 0 | 2 | 0 | 4 | 3 | 7 | 7 | 3 | 13 | 9 | 4 | 0 | 0 | 0 | 0 | 0 | 0 | 3 | 2 | 1 | 2 | 7 | 6 |
| Nucleolus | 1 | 0 | 0 | 2 | 0 | 0 | 3 | 7 | 3 | 5 | 6 | 5 | 2 | 1 | 3 | 1 | 0 | 0 | 1 | 0 | 0 | 0 | 1 | 1 |
| Peroxisomes | 0 | 0 | 0 | 0 | 0 | 0 | 0 | 1 | 0 | 0 | 0 | 0 | 0 | 1 | 2 | 0 | 0 | 0 | 0 | 0 | 0 | 0 | 1 | 0 |
| SpindlePole | 0 | 1 | 0 | 0 | 2 | 0 | 0 | 0 | 2 | 0 | 1 | 1 | 2 | 4 | 12 | 2 | 1 | 1 | 2 | 2 | 1 | 1 | 1 | 2 |
| Vac/Vac Membrane | 322 | 394 | 310 | 303 | 598 | 487 | 568 | 621 | 640 | 526 | 441 | 555 | 282 | 137 | 88 | 207 | 199 | 186 | 398 | 466 | 445 | 424 | 394 | 343 |
| Unique Cell Count | 418 | 499 | 448 | 452 | 815 | 768 | 920 | 1123 | 1138 | 1048 | 983 | 1228 | 502 | 510 | 545 | 420 | 401 | 400 | 462 | 531 | 496 | 488 | 495 | 423 |
| Labelled Cell Count | 468 | 595 | 539 | 593 | 1021 | 983 | 1186 | 1335 | 1464 | 1341 | 1279 | 1594 | 598 | 570 | 598 | 501 | 476 | 464 | 462 | 531 | 496 | 488 | 495 | 423 |
Yeast GFP Assignment
Protein Abundance
| Screen | WT1 | WT2 | WT3 | RAP60 | RAP140 | RAP220 | RAP300 | RAP380 | RAP460 | RAP540 | RAP620 | RAP700 | HU80 | HU120 | HU160 | rpd3Δ_1 | rpd3Δ_2 | rpd3Δ_3 | AF100 | AF140 | AF180 |
|---|---|---|---|---|---|---|---|---|---|---|---|---|---|---|---|---|---|---|---|---|---|
| Mean Cell GFP Intensity (1e-4) | 7.9 | 8.4 | 5.9 | 6.0 | 6.5 | 5.9 | 5.3 | 5.4 | 5.3 | 4.9 | 4.9 | 4.8 | 8.6 | 7.3 | 7.3 | 9.0 | 8.2 | 8.6 | 10.1 | 10.5 | 10.6 |
| Std Deviation (1e-4) | 2.1 | 1.8 | 1.3 | 1.4 | 1.5 | 1.6 | 1.4 | 1.4 | 1.4 | 1.5 | 1.4 | 1.2 | 2.0 | 1.5 | 1.6 | 3.6 | 3.2 | 3.8 | 2.3 | 3.0 | 2.7 |
| Intensity Change (Log2) | – | – | – | 0.02 | 0.13 | -0.02 | -0.17 | -0.13 | -0.18 | -0.28 | -0.27 | -0.31 | 0.54 | 0.29 | 0.29 | 0.6 | 0.47 | 0.54 | 0.77 | 0.82 | 0.83 |
Localization Change
| Localization | RAP60 | RAP140 | RAP220 | RAP300 | RAP380 | RAP460 | RAP540 | RAP620 | RAP700 | HU80 | HU120 | HU160 | rpd3Δ_1 | rpd3Δ_2 | rpd3Δ_3 |
|---|---|---|---|---|---|---|---|---|---|---|---|---|---|---|---|
| Cortical Patches | 0 | 0 | 0 | 0 | 0 | 0 | 0 | 0 | 0 | 0 | 0 | 0 | 0 | 0 | 0 |
| Bud | 0 | 0 | 0 | 0 | 0 | 0 | 0 | 0 | 0 | 0 | 0 | 0 | 0 | 0 | 0 |
| Bud Neck | 0 | 0 | 0 | 0 | 0 | 0 | 0 | 0 | 0 | 0 | 0 | 0 | 0 | 0 | 0 |
| Bud Site | 0 | 0 | 0 | 0 | 0 | 0 | 0 | 0 | 0 | 0 | 0 | 0 | 0 | 0 | 0 |
| Cell Periphery | 0 | 0 | 0 | 0 | 0 | 0 | 0 | 0 | 0 | 0 | 0 | 0 | 0 | 0 | 0 |
| Cytoplasm | 9.4 | 6.7 | 5.9 | 6.9 | 6.5 | 9.0 | 10.4 | 12.2 | 12.5 | 9.9 | 13.1 | 14.8 | 7.2 | 7.6 | 8.8 |
| Endoplasmic Reticulum | 0 | 0.5 | 0 | 0 | 0 | 0 | 0 | 0 | 0 | 0.1 | 5.4 | 4.4 | 0.4 | 2.9 | 2.3 |
| Endosome | -2.9 | -2.6 | -4.4 | -5.2 | -4.9 | 0 | -4.7 | -5.1 | 0 | 2.3 | 2.7 | 4.5 | -1.8 | -1.5 | -2.6 |
| Golgi | 0 | 0 | 0 | 0 | 0 | 0 | 0 | 0 | 0 | 0 | 0 | 0 | 0 | 0 | 0 |
| Mitochondria | -5.7 | -6.2 | -0.8 | 0.2 | -1.2 | 1.1 | 1.4 | 3.3 | 0 | -8.0 | -8.1 | -8.3 | -5.3 | -6.0 | -5.8 |
| Nucleus | -1.6 | -4.9 | 1.0 | -0.5 | 0.2 | -1.2 | -1.6 | -3.3 | -3.8 | -7.1 | -6.8 | -6.9 | 2.2 | 1.1 | -0.1 |
| Nuclear Periphery | 0 | 0 | 0 | 0 | 0 | 0 | 0 | 0 | 0 | 0 | 0 | 0 | 0 | 0 | 0 |
| Nucleolus | 0 | 0 | 0 | 0 | 0 | 0 | 0 | 0 | 0 | 0 | 0 | 0 | 0 | 0 | 0 |
| Peroxisomes | 0 | 0 | 0 | 0 | 0 | 0 | 0 | 0 | 0 | 0 | 0 | 0 | 0 | 0 | 0 |
| SpindlePole | 0 | 0 | 0 | 0 | 0 | 0 | 0 | 0 | 0 | 0 | 0 | 3.2 | 0 | 0 | 0 |
| Vacuole | -0.7 | 1.6 | -2.0 | -2.7 | -5.1 | -4.7 | -6.8 | -8.5 | -8.7 | -4.1 | -13.1 | -17.0 | -6.0 | -5.8 | -6.7 |
External localization resources
Images






























Protein Concentration and Protein Localization Data
| R1 | R2 | R3 | ||||||||||||||||
|---|---|---|---|---|---|---|---|---|---|---|---|---|---|---|---|---|---|---|
| G1 Pre-START | G1 Post-START | S/G2 | Metaphase | Anaphase | Telophase | G1 Pre-START | G1 Post-START | S/G2 | Metaphase | Anaphase | Telophase | G1 Pre-START | G1 Post-START | S/G2 | Metaphase | Anaphase | Telophase | |
| Concentration | 3.9556 | 5.9742 | 5.1661 | 5.0104 | 4.1764 | 5.3695 | 6.319 | 8.8475 | 7.8161 | 7.213 | 7.3614 | 7.8721 | 3.334 | 5.8781 | 5.0642 | 4.4608 | 4.3421 | 5.0699 |
| Actin | 0.0015 | 0.0003 | 0.0003 | 0.0003 | 0.0014 | 0.0003 | 0.0071 | 0 | 0.0008 | 0 | 0 | 0 | 0.023 | 0 | 0.0045 | 0 | 0.0003 | 0.0075 |
| Bud | 0.0032 | 0.011 | 0.002 | 0.0024 | 0.0007 | 0.0028 | 0.0003 | 0.0004 | 0.0004 | 0.0005 | 0.0004 | 0.0005 | 0.0007 | 0.0003 | 0.0004 | 0.0003 | 0.0023 | 0.0004 |
| Bud Neck | 0.0012 | 0.0025 | 0.0016 | 0.0017 | 0.0023 | 0.0024 | 0.001 | 0.0009 | 0.0018 | 0.001 | 0.0018 | 0.0019 | 0.0062 | 0.0058 | 0.0022 | 0.0014 | 0.0018 | 0.0017 |
| Bud Periphery | 0.0018 | 0.005 | 0.0025 | 0.0031 | 0.0021 | 0.0027 | 0.0013 | 0.0011 | 0.0018 | 0.0017 | 0.0015 | 0.0026 | 0.0019 | 0.0013 | 0.0016 | 0.001 | 0.0067 | 0.0017 |
| Bud Site | 0.0013 | 0.0086 | 0.004 | 0.0025 | 0.0038 | 0.001 | 0.001 | 0.0009 | 0.0016 | 0.0027 | 0.0012 | 0.001 | 0.0022 | 0.0014 | 0.0016 | 0.0009 | 0.0035 | 0.0007 |
| Cell Periphery | 0.0041 | 0.0121 | 0.0076 | 0.0121 | 0.0094 | 0.0117 | 0.0126 | 0.0093 | 0.0127 | 0.0095 | 0.0093 | 0.0141 | 0.0048 | 0.0157 | 0.0104 | 0.006 | 0.0047 | 0.0078 |
| Cytoplasm | 0.0084 | 0.0103 | 0.0074 | 0.0134 | 0.0029 | 0.0099 | 0.0065 | 0.0089 | 0.0059 | 0.0026 | 0.0011 | 0.0021 | 0.0067 | 0.0029 | 0.0054 | 0.0013 | 0.0026 | 0.0021 |
| Cytoplasmic Foci | 0.0328 | 0.0087 | 0.0154 | 0.036 | 0.0124 | 0.0072 | 0.0057 | 0.0015 | 0.0034 | 0.0011 | 0.001 | 0.006 | 0.0049 | 0.0044 | 0.0037 | 0.003 | 0.0063 | 0.0011 |
| Eisosomes | 0.0002 | 0 | 0 | 0 | 0 | 0 | 0.0001 | 0 | 0.0002 | 0 | 0 | 0 | 0.0004 | 0 | 0.0001 | 0 | 0 | 0.0001 |
| Endoplasmic Reticulum | 0.0071 | 0.0125 | 0.0165 | 0.0064 | 0.0025 | 0.0066 | 0.021 | 0.0957 | 0.0232 | 0.0064 | 0.0025 | 0.0184 | 0.0136 | 0.014 | 0.0398 | 0.0039 | 0.0032 | 0.0173 |
| Endosome | 0.2083 | 0.0867 | 0.1552 | 0.1442 | 0.1486 | 0.1044 | 0.1632 | 0.0575 | 0.131 | 0.1005 | 0.0657 | 0.0645 | 0.1511 | 0.0792 | 0.1278 | 0.083 | 0.1902 | 0.0695 |
| Golgi | 0.0123 | 0.0036 | 0.0107 | 0.0093 | 0.0394 | 0.0078 | 0.0068 | 0.0032 | 0.0093 | 0.0036 | 0.0014 | 0.0031 | 0.0074 | 0.0026 | 0.0088 | 0.0031 | 0.0148 | 0.0026 |
| Lipid Particles | 0.0331 | 0.0118 | 0.0167 | 0.0131 | 0.0305 | 0.0123 | 0.0382 | 0.0037 | 0.0211 | 0.009 | 0.0035 | 0.0199 | 0.0213 | 0.0087 | 0.014 | 0.0487 | 0.0279 | 0.0054 |
| Mitochondria | 0.0117 | 0.0141 | 0.016 | 0.0083 | 0.0636 | 0.0168 | 0.0092 | 0.0013 | 0.0259 | 0.0013 | 0.0005 | 0.0065 | 0.0121 | 0.0023 | 0.0068 | 0.0005 | 0.0108 | 0.0016 |
| None | 0.0145 | 0.003 | 0.0008 | 0.0099 | 0.0002 | 0.0005 | 0.0012 | 0.0001 | 0.0054 | 0.0001 | 0.0001 | 0.0002 | 0.0011 | 0.0001 | 0.0008 | 0.0001 | 0.0002 | 0.0005 |
| Nuclear Periphery | 0.01 | 0.0084 | 0.011 | 0.0034 | 0.0023 | 0.0065 | 0.0121 | 0.0197 | 0.0227 | 0.0044 | 0.002 | 0.0134 | 0.0206 | 0.0128 | 0.0153 | 0.0055 | 0.0038 | 0.0238 |
| Nucleolus | 0.0074 | 0.0134 | 0.0054 | 0.0036 | 0.0058 | 0.0079 | 0.004 | 0.0009 | 0.0037 | 0.0028 | 0.007 | 0.0056 | 0.0056 | 0.0034 | 0.0034 | 0.003 | 0.0049 | 0.0021 |
| Nucleus | 0.0061 | 0.0072 | 0.0064 | 0.0037 | 0.0036 | 0.0068 | 0.0044 | 0.0042 | 0.004 | 0.0044 | 0.0047 | 0.0064 | 0.0107 | 0.0037 | 0.0108 | 0.0026 | 0.0199 | 0.0049 |
| Peroxisomes | 0.01 | 0.0016 | 0.0077 | 0.0052 | 0.0057 | 0.0012 | 0.0007 | 0.0001 | 0.0005 | 0.0002 | 0.0002 | 0.0005 | 0.0021 | 0.0003 | 0.0003 | 0.0004 | 0.0011 | 0.0001 |
| Punctate Nuclear | 0.0035 | 0.0008 | 0.0011 | 0.0006 | 0.0007 | 0.0002 | 0.0003 | 0.0001 | 0.0006 | 0.0001 | 0 | 0.0002 | 0.0024 | 0.0001 | 0.0002 | 0.0001 | 0.0002 | 0.0004 |
| Vacuole | 0.5108 | 0.6998 | 0.6172 | 0.6534 | 0.5969 | 0.694 | 0.5705 | 0.6547 | 0.6143 | 0.7161 | 0.7819 | 0.7081 | 0.5598 | 0.7199 | 0.6318 | 0.7438 | 0.5994 | 0.7259 |
| Vacuole Periphery | 0.1108 | 0.0785 | 0.0944 | 0.0676 | 0.065 | 0.0973 | 0.1329 | 0.1358 | 0.1098 | 0.1321 | 0.1143 | 0.1251 | 0.1413 | 0.1211 | 0.1102 | 0.0913 | 0.0953 | 0.1227 |
Sequencing Data
| R1 | R2 | |||||||||
|---|---|---|---|---|---|---|---|---|---|---|
| G1 Post-START | S/G2 | Metaphase | Anaphase | Telophase | G1 Post-START | S/G2 | Metaphase | Anaphase | Telophase | |
| Gene Expression | 137.6848 | 109.3104 | 97.0802 | 98.0499 | 121.0902 | 121.2496 | 102.2562 | 108.0761 | 132.9122 | 146.605 |
| Translational Efficiency | 0.253 | 0.2224 | 0.2147 | 0.2695 | 0.2492 | 0.3448 | 0.3029 | 0.2457 | 0.255 | 0.2257 |
Hit Data
| Dataset | Hit |
|---|---|
| Protein Concentration | ✘ |
| Protein Localization | ✘ |
| Gene Expression | ✘ |
| Translational Efficiency | ✘ |
Endocytosis
| Temp | Actin Patch (Sac6-tdTomato) | Cortical Patch (Sla1-GFP) | Late Endosome (Snf7-GFP) | Vacuole (Vph1-GFP) |
|---|---|---|---|---|
| 37℃ | ||||
| RT |
Cell Cycle Omics
CYCLoPs (Cos1-GFP)
| Gene / Allele | Actin Patch (Sac6-tdTomato) | Cortical Patch (Sla1-GFP) | Late Endosome (Snf7-GFP) | Vacuole (Sac6-tdTomato) |
|---|
| Gene | Images |
|---|
| Gene | Images |
|---|
Images are not yet available
Images are not yet available